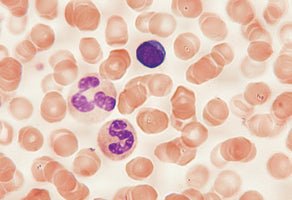

StainRITE® Wright-Giemsa Stain Solution
Product Number:
-
24985
Product Description
Wright-Giemsa Stain Solution is a dual purpose stain useful for blood films, parasites and bone marrow aspirates. Prepared from certified dyes.
Ready-to-use solution makes the differentiation of human blood cells much easier to identify.
Based on a commonly used Azure-Eosin formula.
Stain Results:
Erythrocytes - light pink to moderate purple, not grey or blue
Polymorphonuclear Neutrophils - blue to dark blue to purple nuclei, reddish purple lilac granules, pale pink cytoplasm
Eosinophils - blue to dark blue to purple nuclei, red to orange-red granules, blue cytoplasm
Basophils - purple to dark blue to black nuclei, purple granules
Lymphocytes and monocytes - dark purple nuclei, sky blue cytoplasm
Platelets - violet to purple granules